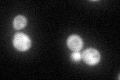
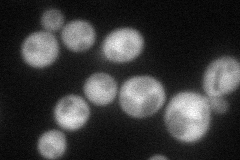
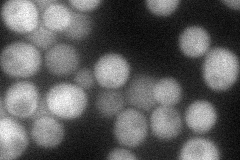
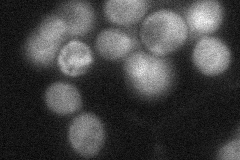
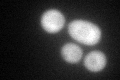
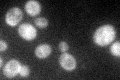

View description
Endoribonuclease; functions in no-go mRNA decay, protein translation to promote G1 progression and differentiation, required for meiotic cell division; similar to the eukaryotic Pelota
Localization:
Intensity:
Fold change:
Significance:
-
C’ GFP library in SD
cytosol65.74 -
N' NOP1pr-GFP in SD
cytosol64.613 -
N' TEF2pr-mCherry in SD
cytosol46.1029 -
N' NATIVEpr-GFP in SD
cytosol31.9496 -
N' TEF2pr-VC and Cyto-VN in SD

below threshold27.194 -
C’ GFP library in SD+DTT
cytosol55.10.83No -
C’ GFP library in SD+H2O2

cytosol59.880.91No -
C’ GFP library in Starvation Media
cytosol89.631.36Yes -
C’ GFP library on the background of Pup2-DaMP

cytosol -
C’ GFP library on the background of CCT mutant

cytosol66.49951.01139No
